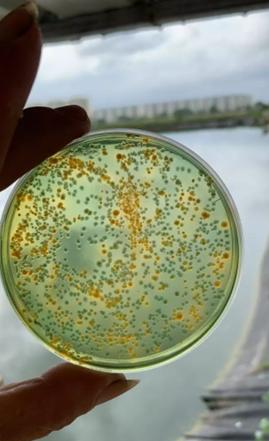
对虾养殖如何自己测弧菌,对虾水产养殖不花钱小妙招

弧菌一直都是对虾养殖中令养殖户最头疼的问题之一,是引起对虾养殖成功率低下的第一因素,尤其在养殖一个月前后,问题尤为严重,每年都有养殖户因为弧菌的问题而损失惨重,弧菌的危害极大,但是并非不可控制。
弧菌为革兰氏阴性致病菌,种类很多,有哈维氏弧菌、溶藻弧菌、副溶血弧菌等。所谓条件致病菌,就是当弧菌数量达到一定水平,对虾体质弱,水体环境恶化的情况下引起对虾疾病。大部分的对虾疾病都是由弧菌感染引起的,例如:对虾偷死、肠炎、空肠空胃、烂鳃、烂眼、荧光等疾病都由弧菌感染引起!弧菌的生长繁殖能力极强,最适环境每8~9分钟为1周期,并能在pH值5~11、温度达到10~42℃等各种恶劣条件下生长繁殖。通常以极生鞭毛运动,有的种在一定条件下可产生固生鞭毛。因此,当对虾感染弧菌后,很难根治,养殖户在养殖过程中应采取措施提前预防弧菌感染,防重于治,并且过程中注意提高虾的体质,能有效减少染病的概率。
一、对虾养殖弧菌困扰着养殖户们,那弧菌的致病源来源于哪呢?
(一)、在我们的养虾过程当中,只是弧菌爆发的主要原因是,养殖条件变差。
比如:水体环境恶化、对虾体质变差等情况发生,那么水体当中、虾体内的弧菌就会迅速繁殖,进而诱发各种对虾疾病。纵观世界各国养峡史,因为弧菌病导致疾病高发的例子比比皆是。在印度尼西亚、台湾、菲律宾、泰国、厄瓜多尔等地都发生过由于哈维氏弧菌,致使斑节对虾和南美白对虾大量死亡的案例。
(二)、致使对虾弧菌病爆发,另一个重要因素就是亲虾或者是虾苗时期,就感染上了弧菌病。
它不仅直接危害亲虾的生存,而且还会影响亲虾受精卵的发育、幼体的发育、虾苗的健康。因为弧菌不仅能寄生在亲虾的肝脏、血液、肌肉当中,而且还能通过遗传感染至无节幼体中,具有破坏性大、传染性强、危害深远的特点。所以,养殖户在购买虾苗之时,对种虾是否健康需要格外关注!同时有条件的话,可以对种虾的虾苗繁育过程做一个全面的了解,因为如果种虾本身没有弧菌病,但是弧菌病还可以通过虾苗繁育过程当中的饲料、水源等,致使种虾、虾苗患上弧菌病!

二、对虾养殖过程中,对虾是如何感染弧菌的?
弧菌体表外生长着许多鞭毛,这种鞭毛随水体的摆动而运动,这样使弧菌更容易与对虾接触,更重要的是弧菌会分泌一种粘附液的物质,通过这种物质,是弧菌更加容易得粘附在对虾的体表之上,从而得到入侵对虾体内的机会。它一旦进入对虾体内后,它会大量繁殖并产生毒素,危害对虾的生存。
三、养殖户应如何操作才能防治对虾养殖过程中弧菌的感染!(一)、养殖户注意这三点,有效预防弧菌发生!
1、选择健康的虾苗
经过分子生物学、镜检等方法,选择健康不带弧菌病原的虾苗,是养殖成功的首要步骤;
2、生物防治法
生物抑制法,在虾池中培养益生菌以形成优势种群,如噬菌体、嗜菌蛭弧菌、光合细菌、乳酸菌、芽孢杆菌等,以及应用海洋微藻,使菌相中有益菌的比例占优势,弧菌比例减少。
3、消毒、灭菌
真正游离在水体中的弧菌较少,弧菌附着在有机碎屑及底部的土壤、地膜和水管表面,大量的弧菌繁殖聚集在一起易形成一层“生物膜”,所以,对弧菌的消毒不建议对水体进行消毒,应该以底部消毒为主,使用过颗粒状或片状的硫酸氢钾盐类的消毒剂直接沉到底部,在局部局域形成高浓度药效区,在12-18小时后补充液态的益生菌,开动氧机让益生菌均匀发布与水体中,这样即可降低弧菌的浓度也有利于培养益生菌形成优势种群的效果。
投喂时,可以搅拌添加乳酸菌投喂,不仅能促进消化,有益肠道健康,提高饵料利用率,降低饵料成本;还能一定程度抑制有害细菌滋生。
【3件7折】乳酸菌超浓 肠道健康 促消化 促长 调水净水 水产养殖 帮邦水产
¥16.9
购买

(二)、弧菌感染不要怕,养殖师傅教你如何治疗弧菌感染!
1. 降盐度:由于弧菌不易在高盐低盐的环境下大量繁殖,这样养殖前期可通过降盐度的方法抑制弧菌繁殖,一般来苗时盐度是20,一天可降低3个盐度,将盐度降到10左右,之后根据当地水体盐度,一天升3个盐度,直至和养殖用水盐度一样,这种方法经过5天就可以将弧菌降到极低的水平。
2. 加大换水量:加大换水量可以将水中的弧菌排出,换入新水,稀释弧菌。
3. 控制温度:温度控制在26-28℃之间,水温低,虾体吃食消化慢,不易将体内的弧菌排出,温度过高,水体中弧菌繁殖较快,易发病。
4. 改底:对于对虾养殖,改底尤为重要,前期使用生物底改,中期交替使用生物底改与化学底改,后期使用化学底改,根据养殖情况改底。插改底片
5. 精准投喂饲料:最好是“少量多次”,一天投喂四餐,每餐控制在1~1.5小时之内食完为好,因为过剩饲料易成为弧菌生长的营养物质。
6. 水源:好的水源是养虾成功的关键,所以选择水源时,要远离化工厂以及养殖猪牛鸡鸭等地。
对虾养殖防重于治,养殖户只有断了弧菌一切会侵蚀对虾的机会,才能保证让弧菌无所遁形,减少虾发病的机会。希望本篇文章能对各位养殖朋友有所帮助,让各位养殖朋友对弧菌的治疗和预防能有一定的了解!